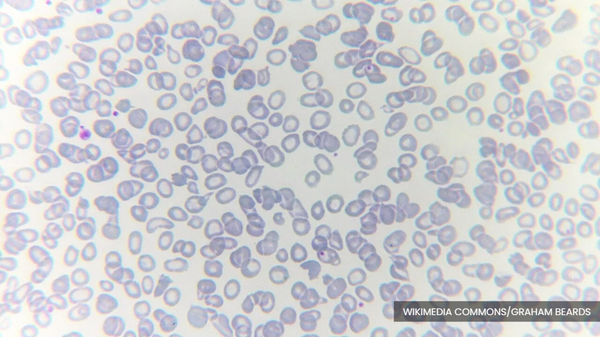
Over 9,500 thalassemia patients treated at RM3m each

KUALA LUMPUR, Feb 23 — Approximately 9,554 thalassemia patients were recorded in the official data from the Annual Report of the Malaysia Thalassemia Registry 2023, published in 2025, involving 102 hospitals under the Health Ministry (MOH), as well as two university hospitals which provide treatment for thalassemia patients.
Health Minister Datuk Seri Dr Dzulkefly Ahmad said the estimated cost of treatment, for patients who depend on blood transfusions, reaches nearly RM3 million per patient, from childhood to the age of 40.
“This amount comprises healthcare costs (92.5 per cent), and out-of-pocket healthcare expenses borne by patients and their families (7.5 per cent).
“Iron chelation therapy is the main contributor to treatment costs, accounting for 56.9 per cent of the total cost, followed by blood transfusion costs at 13.1 per cent,” he said during a question-and-answer session in the Dewan Rakyat today.
Dr Dzulkefly was responding to Kuala Langat MP Dr Ahmad Yunus Hairi's query on the number of thalassemia patients and the treatment costs from childhood to age 40, as well as whether the government plans to develop gene therapy treatment methods in Malaysia.
Commenting on gene therapy, he said the method involves genetically modifying a patient’s stem cells in a laboratory before reintroducing them into the body.
However, the cost of such treatment is extremely high, ranging from about RM10 million to RM13 million per patient, and its implementation is challenging as it requires specialised gene therapy facilities, multidisciplinary expertise, and a sustainable healthcare financing mechanism.
On Hematopoietic Stem Cell Transplantation (HSCT), Dr Dzulkefly said it is a treatment option with the potential to cure transfusion-dependent thalassemia patients in Malaysia, with costs ranging from RM100,000 to RM120,000 per patient.
HSCT services are offered at the Tunku Azizah Hospital and Sabah Women and Children Hospital, with 212 thalassemia patients cured through the method since 2007.
Responding to Dr Yunus's supplementary query on the achievements of the school-based thalassemia programme, he said 2.46 million students have been offered screening, with 57,910 confirmed as carriers of the condition, while Sabah, Selangor, and Kedah recorded the highest numbers.